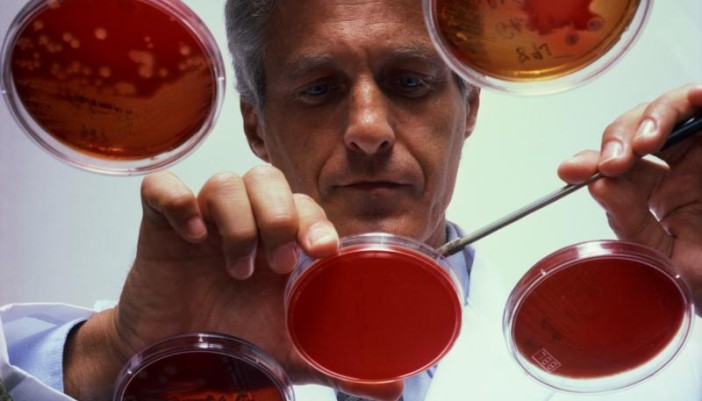

Δοκιμάζεται εμβόλιο για τον καρκίνο στο πάγκρεας
Στην τελική φάση των κλινικών δοκιμών μπαίνει ένα εμβόλιο για τον καρκίνο του παγκρέατος, ο οποίος είναι ένας από τους πιο δύσκολα αντιμετωπίσιμους καρκίνους.
Περισσότεροι από 1.000 βρετανοί πάσχοντες από προχωρημένες μορφές της νόσου δήλωσαν συμμετοχή στην μελέτη TeloVac, η οποία αρχίζει σε 53 βρετανικά νοσοκομεία.
Τα εμβόλια συνήθως σχετίζονται με την πρόληψη των λοιμώξεων αλλά υπάρχουν και άλλα – όπως αυτό που τώρα δοκιμάζεται – τα οποία διεγείρουν το ανοσοποιητικό σύστημα για να καταπολεμά τον καρκίνο.
Κατά την μελέτη, οι μισοί ασθενείς θα κάνουν τακτικά το εμβόλιο GV1001 σε συνδυασμό με χημειοθεραπεία με το φάρμακο γεμσιταμπίνη, ενώ οι άλλοι μισοί θα παίρνουν μόνο γεμσιταμπίνη, για να συγκριθεί η αποτελεσματικότητα των δύο θεραπευτικών προσεγγίσεων.
Το εμβόλιο περιέχει μικρά τμήματα της πρωτεϊνης τελομεράση, η οποία υπερπαράγεται από τα καρκινικά κύτταρα. Στόχος του είναι να διεγείρει το ανοσοποιητικό σύστημα για να αναγνωρίζει την τελομεράση (βρίσκεται στην επιφάνεια των καρκινικών κυττάρων) και να αρχίσει να επιτίθεται στα καρκινικά κύτταρα.
Όπως εξηγεί ο συντονιστής της μελέτης δρ Τζων Νεοπτόλεμος, καθηγητής Χειρουργικής και επικεφαλής του Τμήματος Χειρουργικής & Ογκολογίας στο Πανεπιστήμιο του Λίβερπουλ, το πρόβλημα με τους καρκινικούς όγκους είναι πως μπορούν να «ξεγελούν» τα ανοσοποιητικά κύτταρα και έτσι να προστατεύονται από αυτά.
«Το εμβόλιο εξουδετερώνει την ικανότητα των όγκων να “μεταμφιέζονται” και τους καθιστά εμφανείς στα ανοσοποιητικά κύτταρα», προσθέτει.
Οι πρώτες (φάσης Ι και ΙΙ) δοκιμές του εμβολίου σε πολύ μικρότερους αριθμούς ασθενών έδειξαν πως είναι ασφαλές και αποτελεσματικό στο 75% των περιπτώσεων.
Ο καρκίνος του παγκρέατος είναι ένας πολύ δύσκολος καρκίνος, ο οποίος συχνά γίνεται αντιληπτός σε προχωρημένα στάδια, όταν τα ποσοστά ιάσεώς του είναι πολύ χαμηλά. Μόλις το 3% των ασθενών ζουν με αυτόν πέντε ή περισσότερα χρόνια.
Την μελέτη χρηματοδοτεί ο κορυφαίος οργανισμός έρευνας του καρκίνου στη Βρετανία – το Cancer Research UK.
Ο επιστημονικός διευθυντής του οργανισμού καθηγητής Πήτερ Τζόνζον δήλωσε στο BBC: «Ένα από τα μεγάλα προβλήματα με την θεραπεία του καρκίνου είναι πως σχεδόν πάντοτε εναπομένουν μερικά κακοήθη κύτταρα – και από αυτά μπορεί να αναπτυχθεί εκ νέου ο καρκίνος».
Με τα εμβόλια όπως αυτό που δοκιμάζεται, γίνεται προσπάθεια επαναπρογραμματισμού του ανοσοποιητικού συστήματος, ούτως ώστε να μπορεί να αναγνωρίζει (και) αυτά τα καρκινικά κύτταρα και να τα εκριζώνει ώστε να αποτρέπονται οι υποτροπές του καρκίνου.
Τα αποτελέσματα της μελέτης αναμένονται σε περίπου έναν χρόνο, ενώ αργότερα εφέτος η παρασκευάστρια εταιρεία του εμβολίου προγραμματίζει να αρχίσει αντίστοιχη μελέτη και σε ασθενείς με καρκίνο του πνεύμονα.
Σημειώνεται πως το πρώτο θεραπευτικό εμβόλιο για τον καρκίνο έχει ήδη εγκριθεί για χρήση σε ανθρώπους. Πρόκειται για το Provenge, το οποίο εγκρίθηκε πριν από ένα έτος από την Υπηρεσία Τροφίμων & Φαρμάκων (FDA) των ΗΠΑ για την αντιμετώπιση του προχωρημένου καρκίνου του προστάτη.
Το άρθρο μας έστειλε ο Αποστόλης Γατής, τον οποίο και ευχαριστούμε.